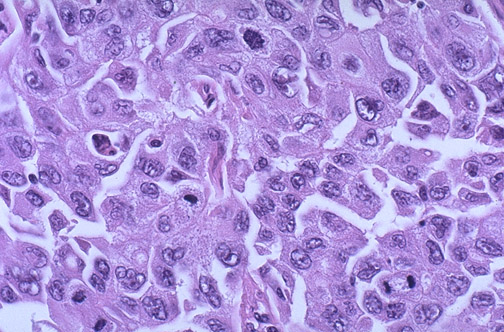

| At high magnification, the rounded, epithelioid cells of a malignant mesothelioma are seen. Mesotheliomas are rare, even in persons with asbestos exposure, and are virtually never seen in persons without a history of asbestos exposure. In addition to the pleura, other but less common sites for occurrence of this neoplasm are the peritoneum, pericardium, and testicular tunica. |
![]() |